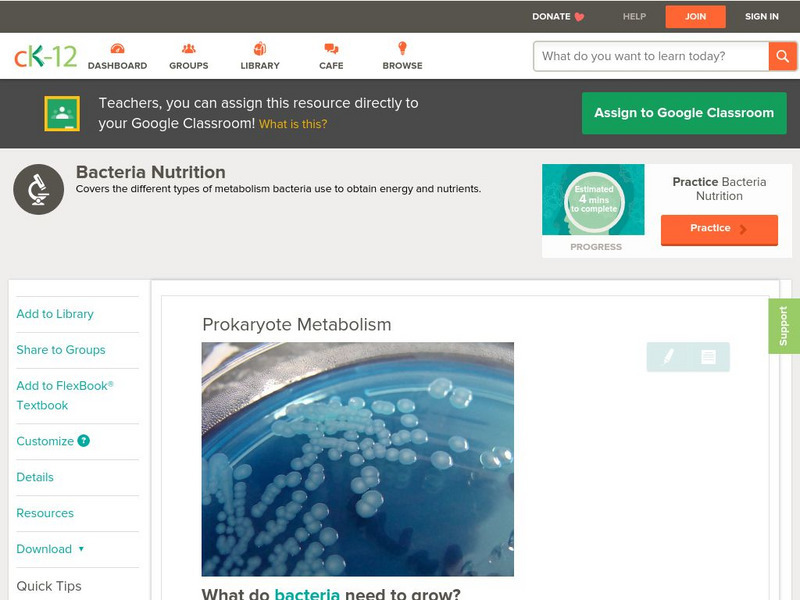

Hi, what do you want to do?
CK-12 Foundation
Ck 12: Episd Biology: Flow of Energy
[Free Registration/Login may be required to access all resource tools.] Students will study how energy flows through an ecosystem and learn about photoautotrophs and chemoautotrophs, the role of decomposers, and of consumers.
CK-12 Foundation
Ck 12: Biology: Flow of Energy
[Free Registration/Login may be required to access all resource tools.] Describes how energy flows through an ecosystem.
CK-12 Foundation
Ck 12: Biology: Prokaryote Metabolism
[Free Registration/Login may be required to access all resource tools.] Describes the different types of metabolism found in prokaryotes.
Biology Pages
Kimball's Biology Pages: The Carbon Cycle
Useful introduction to the carbon cycle with a diagram and a discussion of the effects of carbon dioxide on the greenhouse effect and global warming.